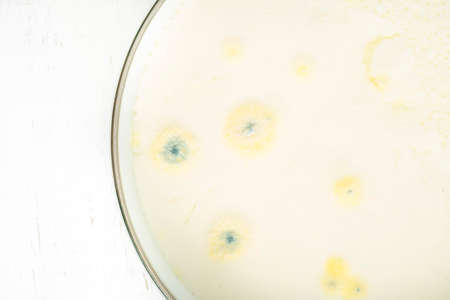
moldy yogurt, growth of mold on yogurt or dairy product food surface exceeded expiry date. rotten yoghurt or milk backgroundの写真素材

写真素材 - moldy yogurt, growth of mold on yogurt or dairy product food surface exceeded expiry date. rotten yoghurt or milk background
作品情報
moldy yogurt, growth of mold on yogurt or dairy product food surface exceeded expiry date. rotten yoghurt or milk background
- ID:180475482
- 作品種別:写真
- 作者名:bbbrrn
キーワード
- abstract
- bacteria
- bad
- butter
- carcinoma
- cheese
- closeup
- cream
- dairy
- damaged
- dangerous
- decay
- details
- disgusting
- expiration
- expiry
- fluid
- food
- fungal
- fungi
- fungus
- glass
- green
- harmful
- jar
- macro
- mildew
- mildewy
- milk
- mold
- molded
- moldy
- musty
- naturale
- nobody
- old
- product
- rod
- rotten
- spoiled
- spores
- texture
- toxic
- unhealthy
- unhygienic
- white
- yoghurt
- yogurt
類似作品
Fruit yogurt wi...
Moldy cup of ho...
Spoiled yogurt ...
Spoiled yogurt ...
Contaminated Br...
Circular mold r...
Mold on a panca...
Food spoilage w...
Mold in food. G...
Moldy yogurt co...
Circular mold r...
Moldy moldy pud...
Jar with mold, ...
mildew in a can...
mold on food, d...
close-up of a c...
Close up of mol...
Concept of mold...
Close up of mol...
Close up of a c...
Contaminated fo...
Backgrounds of ...
Green And Black...
Close-up of mol...
Green And Black...
Tiny Slime mold...
Mold on food. T...
mushrooms, spoi...
musty food, gro...
green and white...
Artistic macro ...
moldy food, top...
Big white mold ...
Close up of mol...
moldy green liq...
A close-up view...
A piece of choc...
Mochi coffee in...
The surface of ...
Fungal mold on ...
Mushroom cultiv...
This image show...
Green And Black...
mold in orange ...
fragment of not...
Empty slide abo...
blue mold backg...
Moldy yoghurt o...
A piece of food...